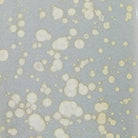

Nouvelle arrivée
Distributeur Worlds Away
Barron Table Lamp
Prix habituel
$925.00
Prix unitaire
/
Indisponible
Impossible de charger la disponibilité pour le Service de retrait
Specifications
SKU: BARRON BLUSH
Vendor: Worlds Away
Dimensions: 30.75"H x 17"DIAM
Garantie du meilleur prix à 110 %
You know you are getting the best Canadian Landed Price at The Rug District. If you find the same product advertised for less by one of our Canadian competitors within 30 days of your purchase, we will gladly match the lower price + 10% of the difference. Contact us for more information.
Delivery: Usually ships in 10-14 days
Barron Table Lamp
Customer reviews